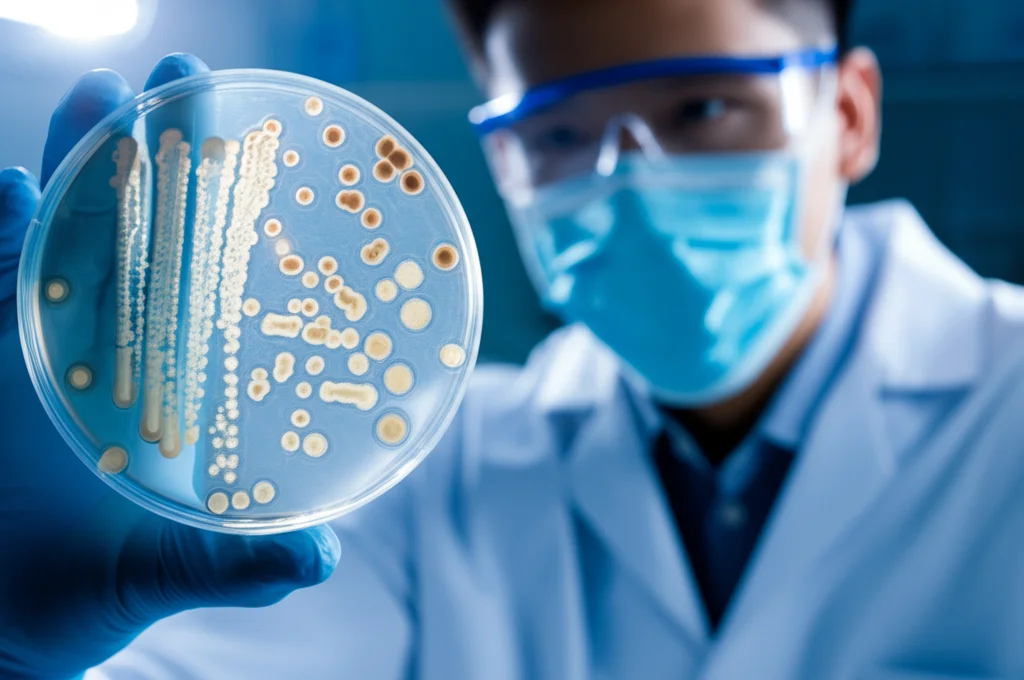
Fotografia di ritratto, lente prime 35 mm, profondità di campo, che mostra uno scienziato in un cappotto da laboratorio che esamina con cura una piastra di pezzi brillante contenente diverse colture microbiche sotto illuminazione controllata, simboleggiando lo studio della funzionalità microbica.

Microrganismi Sotto Stress: Sorprese Funzionali da una Falda Acquifera Contaminata
Avete mai pensato a cosa succede *sotto* i nostri piedi, nelle falde acquifere che custodiscono l’acqua? È un mondo brulicante di vita microscopica, un universo di batteri e archei che lavorano incessantemente. Ma cosa accade quando questo mondo sotterraneo viene messo a dura prova da inquinanti di vario genere? Come reagiscono queste comunità microbiche? È una domanda che mi ha sempre affascinato e che ci ha spinto a indagare più a fondo.
Abbiamo puntato i nostri “microscopi” virtuali su una falda acquifera particolare, quella di Oak Ridge, nel Tennessee (USA). Un sito, diciamo, con un passato industriale pesante, caratterizzato da un cocktail di stress ambientali non indifferente: livelli altissimi di nitrati, metalli pesanti come cadmio e cromo, radionuclidi come l’uranio e, ciliegina sulla torta, un pH estremamente acido, a volte inferiore a 3! Insomma, non proprio un ambiente accogliente.
La Domanda Cruciale: Funzione vs. Forma
Di solito, quando l’ambiente si fa ostile, la prima cosa che osserviamo è un calo della diversità delle specie presenti. Meno “tipi” di microbi riescono a sopravvivere. Questo lo sapevamo, è un classico. Ma la vera domanda che ci siamo posti è stata: la diversità funzionale, cioè la varietà delle “cose” che questi microbi sanno fare (i loro “mestieri”, per così dire), segue lo stesso destino? Crolla anche lei o dimostra una maggiore resistenza?
Per scoprirlo, abbiamo analizzato campioni prelevati da pozzi con diversi livelli di contaminazione, da quelli quasi incontaminati a quelli che definiremmo “zona rossa”. Abbiamo usato tecniche avanzate come il sequenziamento del gene 16S rRNA per capire “chi” c’era (diversità tassonomica e filogenetica) e la metagenomica shotgun per capire “cosa” potevano fare (diversità funzionale, basata sui geni presenti).
Risultati Sorprendenti: Chi Resiste e Chi Cambia
I risultati sono stati, in parte, come ce li aspettavamo, ma con una sorpresa notevole.
- Diversità Tassonomica e Filogenetica in Calo: Come previsto, nei pozzi più contaminati, il numero di “specie” microbiche (la diversità alfa tassonomica) e la loro varietà evolutiva (diversità alfa filogenetica) sono crollati drasticamente. Parliamo di riduzioni superiori all’80% rispetto ai pozzi puliti! Un vero e proprio tracollo.
- La Resilienza della Funzione: Qui arriva la sorpresa. La diversità alfa funzionale, la varietà dei “mestieri” microbici, è diminuita in modo molto più modesto, tanto che la differenza non era nemmeno statisticamente significativa in alcuni indici. È come se, nonostante la perdita di molti “operai” diversi, il set complessivo di “competenze” della comunità microbica rimanesse sorprendentemente robusto. Una sorta di capacità tampone, una resilienza funzionale inaspettata!

Comunità a Confronto: L’Effetto “Anna Karenina” Funzionale
Ma non ci siamo fermati alla diversità *all’interno* di un singolo campione (alfa-diversità). Abbiamo anche confrontato le comunità *tra* i diversi pozzi (beta-diversità). E qui è emerso un altro pattern affascinante.
Mentre le comunità tassonomiche e filogenetiche dei pozzi più inquinati tendevano ad assomigliarsi un po’ di più tra loro (minore dispersione, anche se non statisticamente significativa), per la composizione funzionale è successo l’esatto contrario! Le comunità funzionali nei pozzi ad alta contaminazione erano significativamente *più diverse* l’una dall’altra (maggiore dispersione).
Questo ricorda un po’ il famoso “Principio di Anna Karenina” applicato ai microbiomi: le comunità “sane” (nei pozzi puliti) si assomigliano tutte, mentre quelle “malate” o stressate (nei pozzi inquinati) sono diverse e dissimili ognuna a modo suo, almeno dal punto di vista funzionale. Sembra che lo stress ambientale spinga le comunità a trovare soluzioni funzionali diverse e più eterogenee per sopravvivere.
Cosa Cambia nel “Manuale d’Istruzioni” Microbico?
Andando a vedere quali geni specifici aumentavano o diminuivano, abbiamo avuto un quadro ancora più chiaro di come i microbi si adattano.
- Metabolismo del Carbonio: Molti geni coinvolti nella degradazione di composti complessi del carbonio (come amido, cellulosa, lignina) diminuivano nei pozzi contaminati. Forse perché queste risorse diventano meno importanti o accessibili?
- Ciclo dell’Azoto: Qui la musica cambiava. I geni per la denitrificazione (che trasforma i nitrati, abbondantissimi nei siti contaminati, in gas azoto) aumentavano notevolmente. Logico! Al contrario, geni per la fissazione dell’azoto e la nitrificazione (altre tappe del ciclo) diminuivano.
- Ciclo dello Zolfo: Similmente, aumentavano i geni per la riduzione dei solfati e dei solfiti, processi tipici di ambienti anaerobici (senza ossigeno), come quelli che si creano in condizioni di forte contaminazione.
- Gestione dei Metalli: Un gran viavai! Molti geni legati alla resistenza e al trasporto dei metalli pesanti (mercurio, arsenico, rame, ecc.) aumentavano, come meccanismo di difesa. Altri, però, diminuivano, forse per strategie più complesse di gestione o perché legati a metalli meno problematici in quel contesto.
- Risposta allo Stress: Curiosamente, molti geni legati alla risposta allo stress osmotico (differenze di salinità) e ossidativo diminuivano. Forse perché sopraffatti da stress più gravi o perché la comunità si è adattata a un nuovo “normale”?

Chi Comanda? L’Ambiente Detta le Regole Funzionali
Abbiamo poi cercato di capire cosa influenzasse di più la composizione delle comunità: le caratteristiche chimico-fisiche dell’ambiente (pH, nitrati, metalli, ossigeno…) o la semplice distanza geografica tra i pozzi?
I risultati sono stati netti: le variabili ambientali giocavano un ruolo molto più importante nel plasmare la composizione funzionale rispetto a quanto facessero per la composizione tassonomica o filogenetica. È come se l’ambiente “selezionasse” molto più direttamente le funzioni necessarie per sopravvivere in quel punto specifico, indipendentemente da quale “specie” le svolga. Questo suggerisce che la selezione basata sulla nicchia ecologica è legata più strettamente alla funzionalità microbica che alla sua classificazione tassonomica.
Questo fenomeno è probabilmente legato alla ridondanza funzionale: diverse specie microbiche possono spesso svolgere lo stesso “mestiere”. Quindi, anche se alcune specie scompaiono a causa dello stress, altre possono prenderne il posto, mantenendo attiva quella funzione essenziale e spiegando perché la diversità funzionale complessiva cala meno di quella tassonomica.
I Protagonisti dell’Adattamento
Dando un’occhiata più da vicino a “chi” prosperava negli ambienti più ostili, abbiamo trovato alcuni protagonisti interessanti. Il genere Rhodanobacter, un tipo di Proteobacteria noto per la sua capacità di denitrificare e tollerare i metalli pesanti, diventava incredibilmente dominante nei pozzi più contaminati, arrivando a costituire l’80% della comunità in un caso! Altri generi, come Sulfurifustis (coinvolto nel ciclo dello zolfo e resistente al cadmio) e membri del phylum Eremiobacterota (forse coinvolti nell’ossidazione del ferro), erano anch’essi più abbondanti in condizioni di stress. Questo ci conferma che specifiche popolazioni microbiche si specializzano per affrontare le sfide uniche del loro ambiente.
Perché Tutto Questo è Importante?
Capire come le comunità microbiche rispondono allo stress a livello funzionale non è solo una curiosità scientifica. Ha implicazioni enormi.
- Bioremediation più Efficace: Se sappiamo quali funzioni sono cruciali per degradare certi inquinanti o immobilizzare metalli pesanti, possiamo monitorare i geni corrispondenti per valutare l’efficacia dei trattamenti di bonifica (bioremediation) o addirittura stimolare le funzioni desiderate. L’eterogeneità funzionale che abbiamo osservato potrebbe spiegare perché a volte la bonifica in situ è difficile: le condizioni locali favoriscono “soluzioni” microbiche diverse.
- Indicatori di Salute Ambientale: La composizione funzionale potrebbe essere un indicatore più sensibile e informativo dello stato di salute di un ecosistema rispetto alla sola tassonomia.
- Modelli Idrogeochimici Migliori: Integrare la conoscenza della funzionalità microbica nei modelli che descrivono il flusso dell’acqua e il destino degli inquinanti nel sottosuolo può renderli molto più accurati e predittivi.
In conclusione, il nostro viaggio nel sottosuolo contaminato di Oak Ridge ci ha mostrato che le comunità microbiche, anche se duramente colpite nella loro diversità di specie, mantengono una sorprendente capacità di svolgere i loro compiti essenziali. La loro funzionalità è resiliente, ma anche plastica e altamente influenzata dalle condizioni locali, portando a una maggiore eterogeneità funzionale sotto stress. Guardare a “cosa fanno” i microbi, e non solo a “chi sono”, è fondamentale per comprendere e gestire questi ambienti complessi e preziosi.
Fonte: Springer







